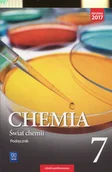
Podręczniki dla szkół podstawowych - WSIP Wydawnictwa Szkolne i Pedagogiczne Świat chemii 7 Podręcznik - miniaturka - grafika 1

Tanie podręczniki szkolne
Wróć do Księgarnia
- Edukacja przedszkolna
- Encyklopedie i leksykony
- Materiały pomocnicze dla nauczycieli
- Materiały pomocnicze dla uczniów
- Podręczniki dla gimnazjum
- Podręczniki dla liceum
- Podręczniki dla szkół podstawowych
- Podręczniki dla szkół wyższych
- Podręczniki dla szkół zawodowych
- Podręczniki do technikum
- Słowniki języka polskiego